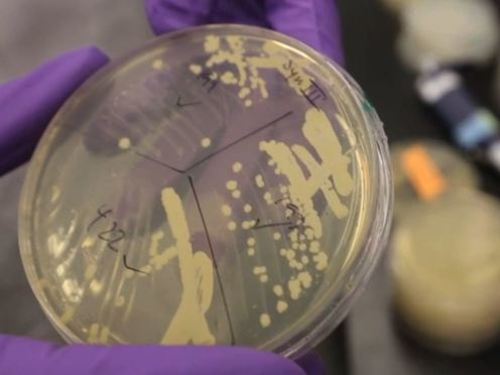

comunicacion
actualidad
CATEGORÍA: Sanidad
Competencia avala el sistema de doble precio en los medicamentos
15 marzo 2017
El organismo respalda que los laboratorios impongan un importe libre
Hacia la creación de vida compleja artificial
10 marzo 2017
La producción de cinco nuevos cromosomas artificiales acerca la posibilidad de fabricar un organismo complejo
El MIT premia al hospital Peset por un proyecto que reduce el dolor al poner la epidural
10 marzo 2017
El instituto tecnológico norteamericano reconoce el avance del proyecto que evita perforaciones indeseadas
Los neandertales ya se automedicaban
09 marzo 2017
Un análisis genómico aclara cómo era la dieta de los antiguos europeos
Sanidad lanza un plan para prevenir patologías crónicas con la comida
08 marzo 2017
El personal sanitario se formará en cómo mejorar las pautas nutricionales. Los pacientes realizarán talleres para saber alimentarse de forma saludable
1
2
3
4
5
6
7
8
9
10
11
12
13
14
15
16
17
18
19
20
21
22
23
24
25
26
27
28
29
30
31
32
33
34
35
36
37
38
39
40
41
42
43
44
45
46
47
48
49
50
51
52
53
54
55
56
57
58
59
60
61
62
63
64
65
66
67
68
69
70
71
72
73
74
75
76
77
78
79
80
81
82
83
84
85
86
87
88
89
90
91
92
93
94
95
96
97
98
99
100
101
102
103
104
105
106
107
108
109
110
111
112
113
114
115
116
117
118
119
120
121
122
123
124
125
126
127
128
129
130
131
132
133
134
135
136
137
138
139
140
141
142
143
144
145
146
147
148
149
150
151
152
153
154
155
156
157
158
159
·siguientes

Farmacias abiertas y de urgencia más cercanas
Farmacias abiertas y de urgencia más cercanas